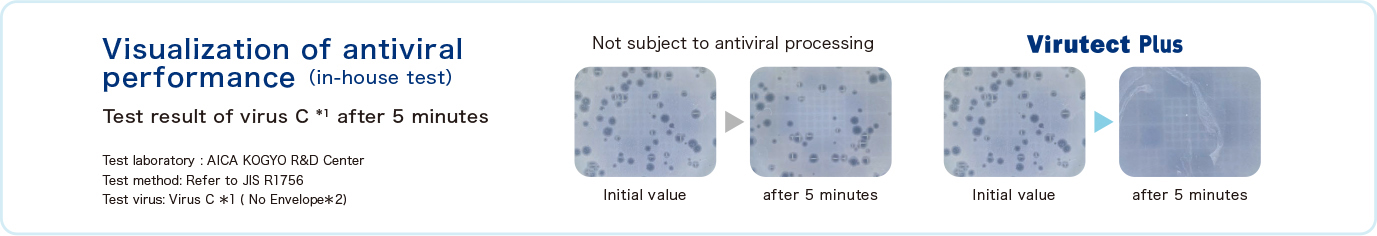
Picture of features

- HOME
- Product Information
- Decorative Panels
- High Pressure Laminates
Decorative Panels
Our high pressure laminates come in a rich variety of color patterns and offer amazing durability. They are used as surface materials in tables and other furniture found in shops, hospitals, offices and more.
Product list
| General name | Product Name | Size | Thickness (mm) | Feature Notes |
|---|---|---|---|---|
| Anti finger print high pressure laminate | CELSUS Premium Texture | 4'×8' | 0.95 | High pressure laminates with synchronised embossing |
| Anti virus high pressure laminate | AICA Virutect Plus | 4'×8' | 0.95 | High pressure laminates with antiviral, antibacterial and deodorization feature |
| Anti virus high pressure laminate | AICA Virutect | 4'×8' | 0.95 | High pressure laminates with antiviral and antibacterial feature |
| Anti virus high pressure laminate with pressure-sensitive adhesive | Melatack Virutect | 3'×6' 4'×8' 595×595mm 895×895mm |
0.55 | High pressure laminate sheets with antiviral, antibacterial and deodorization feature |
| High pressure laminate with pressure-sensitive adhesive | Melatack plus | 3'×6' 4'×8' |
0.55 | High pressure laminate sheets which are certified for fire protection |
| Oil repellent high pressure laminate | Melaclean | 4'×8' | 0.95 | High pressure laminates with oil repellent feature |
| Thin fire retardant high pressure laminate | Flaretect | 3'×6' 4'×8' |
0.7 | High pressure laminate sheets which are certified for fire protection |
| Scratch Resistant high pressure laminate | Scratchless | 3'×6' 4'×8' |
0.95 | High pressure laminates which will not become scratched even if rubbed with steel wool |
| Anti finger print high pressure laminate | AICA CELSUS | 3'×6' 4'×8' |
0.95 | High pressure laminates with anti-fingerprint feature |
| High pressure laminate | AICA HPL | 3'×6' 4'×8' |
0.95 | Normal high pressure laminates |
| Rabian | ||||
| COLOR SYSTEM FIT | ||||
| Same color core high pressure laminate | AICA Core | 3'×6' 4'×8' |
1.2 | Solid color high pressure laminates with cores of the same color |
| Chemical resistant special acrylic resin high pressure laminate | Chemitect | 3'×6'~ | 1.2 | High pressure laminates with excellent resistance against chemicals |
| Metal foil laminate | Metal laminate | 4'×8' | 0.8~ | High pressure laminates with metal foil |
Features
High Pressure Laminate Features
"High Pressure Laminates" are laminated plastic sheets which have been formed under high temperatures (150°C) and high pressures (approx. 100 kg/cm2). The process involves stacking multiple sheets which have each been impregnated with melamine and phenol resins and then dried onto one another. The surface layer consists of melamine resin while the central core layers consist of phenol resin.
HPL with Sharpest Surface Color
AICA High Pressure Laminate come in five colors suited to match different surface colors and patterns: white core, gray core, yellow core, brown core, and black core. Our Color System Fit achieves deeper blacks, drab-free whites, and more vivid colors by optimizing surface patterns and core colors.
-

White Core
-

Gray Core
-

Yellow Core
-

Brown Core
-

Black Core
Environmental compatibility
AICA melamine decorative laminated sheets have acquired Biomass Mark certification
AICA Melamine Decorative Laminated Sheets, Decorative Polyester Plywood, and AICA Marless Boards have all earned the Biomass Mark certification.
The Biomass Mark is displayed on environmental products that utilize biologically-derived resources (biomass), and which meet quality and safety-related regulations, specifications, and standards.
"Biomass rate" refers to the percentage of biomass used in the product which is reflected in the Biomass Mark in units of 10%.
- The Biomass Mark is a Japanese domestic certification mark based on Japanese regulations.
- Since plants grow by using natural sunlight as energy and by absorbing carbon dioxide in the air, the carbon dioxide emitted when they are burned is simply returned to the air and therefore is not counted as a greenhouse gas. This type of structure is called "carbon neutral."
Melamine decorative laminated sheets are products with seft-declared conformity for 4 VOCS
A self-declaration of conformity is a "declaration" of responsibility by AICA to conform to all 4 VOC (toluene, xylene, styrene, and ethylbenzene) emission rate standards*.
- "VOC emission rate standards from building materials" as enacted by "Committee for standardization of emission rate of VOC from building products"
AICA Virutect Plus
In addition to antiviral and antibacterial feature, deodorization feature has also been added!
We have seen many requests for deodorization feature in lavatories at schools, commercial facilities, train stations, and at hospitals and nursing care facilities. That is why we have gone ahead and added that to this product for even greater ease of use.
-

Yuuzenkai Shinhassamu Family Clinic
AICA Virutect YJY2051K -

Mirai Gakuen Maebashi Medical Welfare college
Pure Core Booth Rescue Open type
Panel:Aica Virutect YK-6000KN
Door:Aica Virutect YJY2050K
Features
- Because specific virus names cannot be shown for reasons related to the Pharmaceutical and Medical Devices Act (Act on Securing Quality, Efficacy and Safety of Products including Pharmaceutical and Medical Devices), the virus is shown as Virus A, Virus B and Virus C
- Membranous structure found in virus particles, it is said that if there is no envelop, resistance to disinfectants such as alcohol is stronger than having an envelope.
- PFU (Plaque-Forming Unit) An index of the number of viruses measured from the number of plaques.
Cautions
- These are measured values and are not guaranteed values.
- This is our own testing method. It does not guarantee the effects in actual usage environments.
- This does not guarantee semi-permanent effects.
- No deodorization feature has been added to AICA Virutect.
Specification
| Size | 3'×6' 4'×8' |
|---|---|
| Thickness (mm) | 0.95 |
Cautions
- Anti-Viral is not intended to treat or prevent disease.
- These products meet SIAA safety criteria.
- These products do not guarantee the prevention of infection.
- Anti-Viral and bacterial performance is not expressed against all viruses and bacterium. In addition, the same test results cannot necessarily be obtained for all viruses and bacterium.
- These are the results of the test laboratory and the same effects are not guaranteed under actual conditions of use.
- These are not products intended for medical use such as pharmaceuticals or medical devices.
- If the surface is worn to the extent that the gloss changes, antiviral and antibacterial performance may be degraded.
- If the surface is coverd with dirt or other contaminants, antiviral and antibacterial performance will not be effective, so please take proper care of it.
- Even with the same pattern number, the color and gloss of the Virutect and Virutect Plus are different, so please avoid using them together on the same surface of the same property and item.